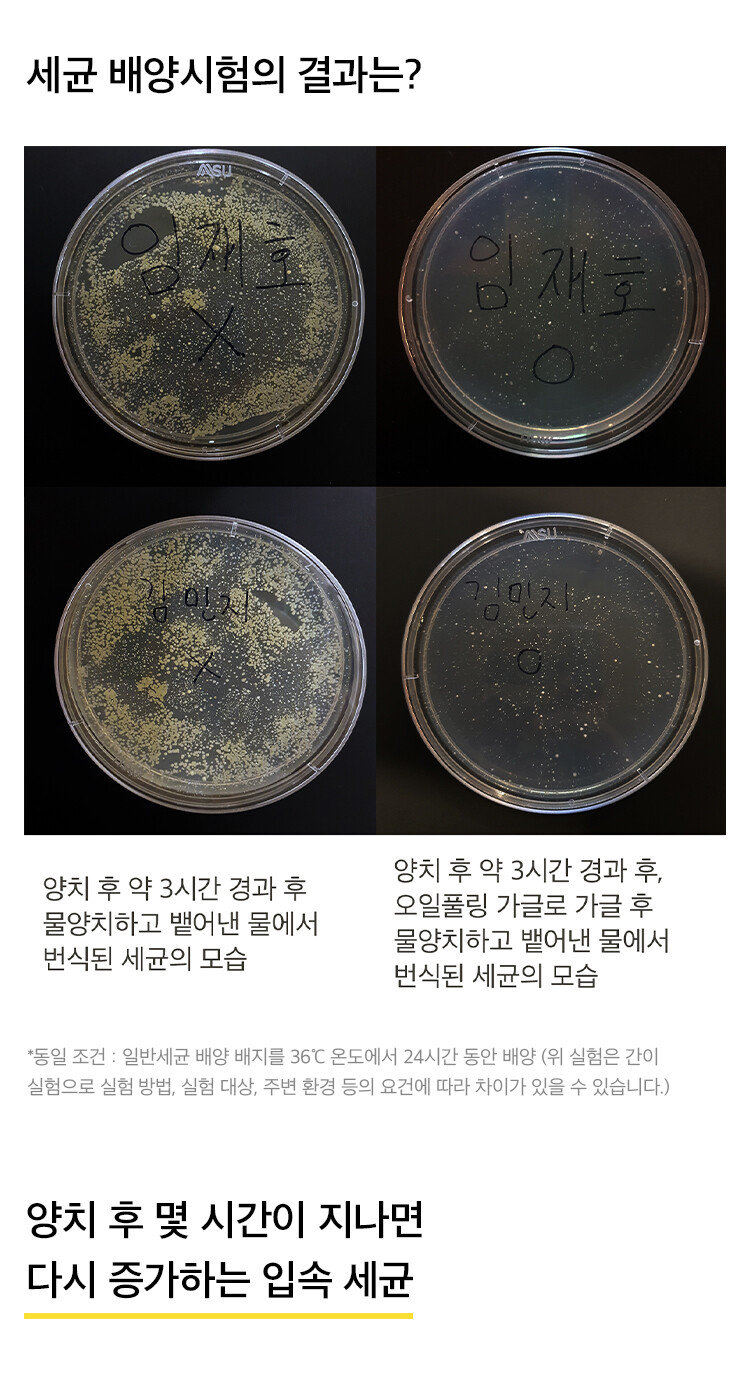

입냄새완화 임산부 사용가능한 비건가글 오일풀링 가글 11mL 24개입 (3팩)
크라우드 펀딩 1위의 역사, 순한 가글 오일풀링으로 구강 관리의 새로운 경험을 여세요.
34,000원
43,200원
배송비
-
수량
주문 수량
0개
총 상품 금액
0원

*상품결제안내
고액결제의 경우 안전을 위해 카드사에서 확인전화를 드릴 수도 있습니다.
확인과정에서 도난 카드의 사용이나 타인 명의의 주문 등 정상적인 주문이 아니라고 판단될 경우, 임의로 주문을 보류 또는 취소할 수 있습니다.
무통장 입금은 상품 구매 대금은 PC뱅킹, 인터넷뱅킹, 텔레뱅킹 혹은 가까운 은행에서 직접 입금하시면 됩니다.
주문시 입력한 입금자명과 실제입금자의 성명이 반드시 일치하여야하며, 7일 이내로 입금을 하셔야하며 입금되지 않은 주문은 자동취소됩니다.
*상품배송안내
기본배송료는 3,000원이며 30,000원 이상 구매시 무료배송입니다.
산간벽지나 도서지방, 오지 등의 일부지역과 해외의 경우, 별도의 배송비(4,000원)가 추가되어 안내될 수 있습니다.
고객님께서 주문하신 상품은 입금 확인 후 배송해드립니다. 다만, 상품 종류에 따라서 상품의 배송이 다소 지연될 수 있습니다.
제품 구매 후 주말 제외 2-3일 이내에 발송되며, 택배사 사정에 의해 지연될 경우가 생길 수 있습니다.
*교환반품안내
교환 및 반품이 가능한 경우
- 교환 및 반품은 상품 수령일로부터 주말 제외, 7일 이내에 가능합니다.
- 상품 태그 제거 또는 제품 개봉·사용·훼손 시에는 7일 이내라도 교환 및 반품이 불가능합니다.
- 제품 하자, 배송오류를 제외하고 고객 변심에 의한 교환 및 반품은 고객님께서 배송비를 부담하셔야 합니다.
교환 및 반품이 불가능한 경우
- 고객님의 책임 있는 사유로 상품 등이 멸실 또는 훼손된 경우. 단, 상품의 내용을 확인하기 위하여 포장을 훼손한 경우는 제외.
- 포장을 개봉하였거나 포장이 훼손되어 상품가치가 상실된 경우.
- 고객님의 사용 또는 일부 소비에 의하여 상품의 가치가 현저히 감소된 경우
- 시간의 경과에 의하여 재판매가 곤란할 정도로 상품 등의 가치가 현저히 감소한 경우
- 복제가 가능한 상품 등의 포장을 훼손한 경우
(자세한 내용은 고객상담실 02-388-3927(평일 오전 11시~오후6시)이나 E-mail, hhealthcare.inc@gmail.com 으로 문의주시기 바랍니다.)
입냄새완화 임산부 사용가능한 비건가글 오일풀링 가글 11mL 24개입 (3팩)
34,000원
43,200원
수량
주문 수량
0개
총 상품 금액
0원
